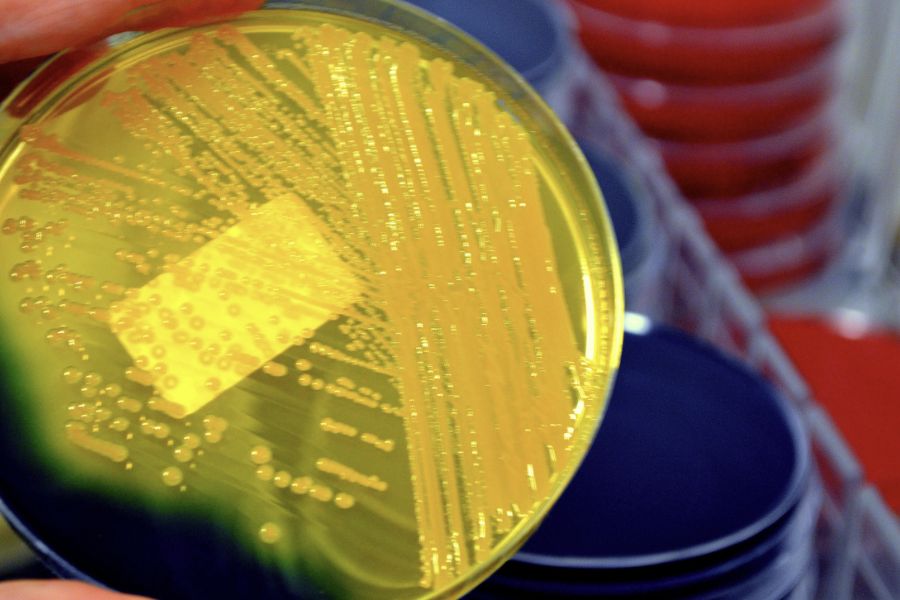
계절이 바뀔 때마다 달라졌던 위생 느낌과 세균막(바이오필름)연관성

📑 목차
계절이 바뀔 때마다 달라지던 집안의 위생 느낌, 그 원인을 세균막(바이오필름) 관점에서 풀어봅니다. 청소를 해도 반복되던 찝찝함의 이유와, 계절 변화 속에서도 위생을 유지하는 관리 기준을 경험을 통해 정리했습니다.
계절이 바뀔 때마다 달라졌던 위생 느낌은 필자에게 늘 막연한 불편함으로 남아 있었다. 봄과 가을에는 비교적 쾌적하게 느껴지던 집이, 여름만 되면 유독 찝찝해지고, 겨울에는 또 다른 방식으로 불편해졌다. 같은 집, 같은 공간, 같은 청소 방식인데도 체감되는 위생 상태가 계절에 따라 달라진다는 점은 오랫동안 설명되지 않는 의문이었다. 그동안 필자는 이를 단순히 “날씨 탓”, “기분 탓”, 혹은 “계절 특성” 정도로 받아들여 왔다.
하지만 시간이 지날수록 그 차이는 점점 분명해졌다. 여름에는 바닥과 욕실이 쉽게 미끈해졌고, 장마철에는 청소 직후에도 찝찝함이 빠르게 돌아왔다. 반대로 건조한 계절에는 같은 관리 방식임에도 상대적으로 안정적인 위생 상태가 유지되었다. 이 반복 속에서 필자는 처음으로 “계절 변화가 위생에 영향을 주는 구조적인 이유가 있지 않을까?”라는 질문을 하게 되었다. 이후 세균막(바이오필름)이라는 개념을 접하면서, 계절이 바뀔 때마다 달라졌던 위생 느낌이 단순한 감각의 문제가 아니라 생활환경 속에서 실제로 작동하던 위생 구조의 변화라는 점을 이해하게 되었다.
원인→계절별 위생 차이를 ‘관리 부족’으로만 해석했던 한계
계절이 바뀔 때마다 달라졌던 위생 느낌의 원인을 필자는 오랫동안 자신의 관리 부족에서 찾았다. 여름철 집이 유독 찝찝해지면 “요즘 청소를 덜 했나 보다”라고 생각했고, 장마철 불편함이 반복되면 자연스럽게 “청소 주기를 더 줄여야겠다”는 결론에 도달했다. 위생 문제는 결국 개인의 부지런함과 성실함에 달려 있다고 믿었고, 계절이라는 요소는 그저 컨디션이나 환경 탓을 하기 위한 핑계에 불과하다고 여겼다.
그래서 계절이 바뀔 때마다 필자의 대응 방식은 늘 같았다. 더 자주 바닥을 닦고, 더 강한 세정제를 사용하고, 눈에 보이는 오염이 없어도 불안한 마음에 한 번 더 청소했다. 하지만 이 노력은 이상하리만큼 결과로 이어지지 않았다. 특히 여름과 장마철에는 청소 직후 잠깐의 만족감만 있을 뿐, 하루나 이틀이 지나면 다시 같은 찝찝함이 되돌아왔다. 반대로 겨울이나 건조한 계절에는 상대적으로 관리 강도가 낮아도 쾌적함이 유지되었다.
이 차이는 필자에게 점점 큰 의문으로 남았다. 분명 관리량은 더 늘었는데, 체감되는 위생 상태는 오히려 더 나빠졌기 때문이다. 이때까지 필자는 ‘노력의 양’만을 기준으로 위생을 판단하고 있었고, 청소 이후 공간이 어떤 상태로 유지되는지는 거의 고려하지 않았다. 세균막(바이오필름)이라는 개념은 바로 이 지점에서 기존 해석의 한계를 분명하게 드러냈다. 위생 상태는 청소 행위 자체보다, 계절에 따라 달라지는 습도·온도·건조 속도 같은 환경 조건에 훨씬 더 크게 좌우되고 있었던 것이다.
구조 설명→계절 변화가 세균막(바이오필름) 환경을 바꾸는 방식
세균막(바이오필름) 관점에서 계절 변화를 다시 바라보자, 위생 체감이 달라지는 구조는 매우 명확해졌다. 세균막은 단순히 더러워서 생기는 것이 아니라, 물기와 영양원이 남아 있고, 적당한 온도와 공기 흐름 부족이 일정 시간 유지될 때 표면에 형성된다. 중요한 점은 이 조건들이 고정된 것이 아니라, 계절에 따라 크게 달라진다는 사실이었다.
여름과 장마철에는 실내 습도가 높아지고, 물기가 자연스럽게 마르는 속도가 눈에 띄게 느려진다. 욕실 바닥이나 주방 싱크대처럼 물 사용이 잦은 공간은 물론이고, 비누 받침대 아래, 배수구 주변, 수세미와 청소 도구처럼 작은 물건들까지도 젖은 상태가 오래 유지된다. 이 상태는 세균막(바이오필름)이 유지되기에 거의 최적의 조건에 가깝다. 겉으로는 깨끗해 보여도, 표면에서는 보이지 않는 막이 계속 살아남는다.
반대로 겨울이나 건조한 계절에는 같은 공간, 같은 사용 방식이라도 물기가 훨씬 빠르게 사라진다. 표면이 완전히 마르는 시간이 짧아지면서 세균막이 유지될 여지가 줄어든다. 필자는 이 구조를 이해하며 중요한 사실 하나를 받아들이게 되었다. 공간 자체는 변하지 않지만, 계절은 그 공간이 어떤 위생 상태를 유지할 수 있는지를 결정하는 환경 조건을 끊임없이 바꾸고 있었다는 점이다. 계절이 바뀔 때마다 달라졌던 위생 느낌은 주관적인 기분이 아니라, 세균막이 유지되는 ‘시간의 길이’ 차이에서 비롯된 매우 현실적인 결과였다.
실제 사례→계절이 바뀔 때마다 달라졌던 위생 체감의 경험
계절이 바뀔 때마다 달라졌던 위생 느낌은 필자의 일상 속에서 매우 구체적인 장면들로 남아 있다. 여름철 욕실 바닥은 샤워 후 물기를 닦아내도 다음 날이면 다시 미묘한 미끈함이 느껴졌다. 눈으로 보기에는 깨끗했지만, 맨발로 들어섰을 때의 촉감은 분명히 달랐다. 특히 비누 받침대 아래나 배수구 주변은 청소를 반복해도 항상 비슷한 찝찝함으로 돌아왔다.
주방에서도 상황은 크게 다르지 않았다. 여름이 되면 수세미와 행주에서 냄새가 훨씬 빨리 올라왔고, 텀블러 바닥에서는 아무리 씻어도 설명하기 어려운 향이 남았다. 반면 겨울에는 같은 관리 방식임에도 이런 문제가 상대적으로 적었고, 청소 결과도 며칠씩 유지되었다. 이 차이는 단순히 ‘덜 더러워서’라기보다, 뭔가 다른 조건이 작동하고 있다는 느낌을 주었다.
이 경험들이 세균막(바이오필름)이라는 개념과 만나면서 비로소 하나의 흐름으로 연결되었다. 계절 변화는 위생 상태를 직접 만들어내는 원인이 아니라, 세균막이 살아남을 수 있는 시간을 늘리거나 줄이는 배경 조건이었다. 필자가 계절마다 느꼈던 위생 차이는 바로 그 조건 변화의 결과였던 것이다.
증상 정리→계절 변화 속 세균막(바이오필름)이 보내는 신호
계절이 바뀔 때마다 반복되던 위생 문제에는 분명한 공통 신호가 있었다. 첫째, 청소 직후에는 비교적 괜찮아 보이지만, 습한 계절일수록 그 상태가 유지되는 시간이 눈에 띄게 짧아졌다. 둘째, 눈에 보이는 오염이나 곰팡이는 없는데도 촉감이 미묘하게 변하고, 은근한 냄새나 찝찝함이 남았다. 셋째, 같은 공간에서도 특정 계절에만 문제가 집중적으로 나타났다.
이 증상들은 필자에게 중요한 메시지를 전달하고 있었다. 이는 “청소가 부족하다”는 경고가 아니라, “세균막(바이오필름)이 유지될 환경이 만들어졌다”는 신호였다. 계절 변화는 위생 문제를 새롭게 만들어내는 것이 아니라, 이미 존재하던 구조를 강화하거나 약화시키는 역할을 하고 있었던 것이다.
이 사실을 인식한 이후 필자는 계절이 바뀔 때마다 위생 상태를 자책하기보다, 환경 조건이 어떻게 달라졌는지를 먼저 점검하게 되었다. 세균막(바이오필름)은 계절별 위생 차이를 이해하게 만든 가장 설득력 있는 기준으로, 필자의 생활위생 인식을 한 단계 끌어올려 주었다.
결론→계절 변화에도 흔들리지 않는 세균막(바이오 필름)중심 위생 기준
모든 경험을 종합하며 필자는 계절이 바뀔 때마다 달라졌던 위생 느낌의 핵심 원인이 세균막(바이오필름)에 있다는 결론에 도달했다. 그동안 필자는 계절이 바뀔 때마다 위생 상태가 흔들리면, 그때그때 더 열심히 닦고 더 자주 청소하는 방식으로 대응해 왔다. 하지만 이 방법은 늘 임시방편에 불과했고, 계절이 만들어내는 환경 조건 앞에서는 쉽게 한계를 드러냈다. 해결의 방향은 계절마다 관리 강도를 높이는 것이 아니라, 계절이 바뀌어도 세균막이 유지될 수 없는 환경을 만드는 데 있었다.
이 판단 이후 필자의 위생 기준은 계절에 따라 보다 명확하게 조정되기 시작했다. 습도가 높아지는 여름과 장마철에는 청소 자체보다 물기를 얼마나 빠르게 제거했는지, 공기가 얼마나 잘 순환되었는지를 가장 중요한 기준으로 삼았다. 욕실과 주방은 사용 직후 환기를 기본 동작으로 설정했고, 바닥과 표면에 남은 물기는 ‘자연히 마르겠지’라고 넘기지 않고 의식적으로 처리했다. 반대로 비교적 건조한 계절에도 이 습관을 완전히 놓지 않았다. 건조한 환경은 세균막 형성을 늦춰줄 뿐, 방심하면 다시 같은 구조가 만들어질 수 있다는 사실을 이미 경험으로 알고 있었기 때문이다.
이 과정에서 청소의 의미 자체도 달라졌다. 이전에는 청소가 끝나는 시점이 ‘닦아낸 순간’이었다면, 이제는 ‘완전히 마른 상태가 되었는가’가 청소의 종료 기준이 되었다. 눈에 보기엔 크게 차이가 없어 보여도, 계절 조건 속에서 표면이 어떤 상태로 남아 있는지를 점검하는 습관이 생겼다. 그 결과 계절이 바뀌어도 집안의 촉감과 냄새는 이전처럼 크게 흔들리지 않았고, 위생 상태 역시 훨씬 안정적으로 유지되었다.
이제 필자에게 계절 변화는 위생을 무너뜨리는 불안 요소가 아니다. 오히려 관리 방식을 점검하고 기준을 조정해야 할 시점을 알려주는 신호에 가깝다. 세균막(바이오필름)은 계절이 바뀔 때마다 달라졌던 위생 느낌을 이해하게 해 준 결정적인 개념이자, 환경에 휘둘리지 않는 생활 위생 기준을 세우게 해 준 토대가 되었다. 지금도 이 기준은 필자의 일상 속에서 조용하지만 분명하게 작동하며, 계절과 상관없이 안정적인 위생 감각을 유지하도록 이끌고 있다.
'세균막(바이오필름)' 카테고리의 다른 글
| 도마 위생 문제를 다시 보게 만든 세균막(바이오필름) (0) | 2025.12.18 |
|---|---|
| 물 사용이 많은 곳과 적은 곳의 차이로 드러난 생활 위생의 본질 – 세균막(바이오필름) (0) | 2025.12.17 |
| 물병 입구를 닦다 멈칫했던 순간과 세균막(바이오필름) (0) | 2025.12.17 |
| 세균막(바이오필름)을 알고 나서 달라진 일상 관리 기준의 시작 (0) | 2025.12.17 |
| 세균막(바이오필름)을 통해 배우게 된 생활 위생의 중요성 (0) | 2025.12.17 |